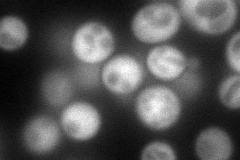
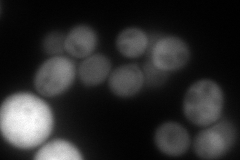
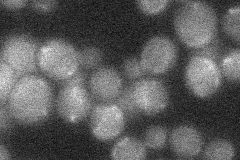
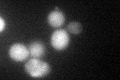
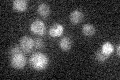

View description
Putative tryptophan 2,3-dioxygenase or indoleamine 2,3-dioxygenase, required for the de novo biosynthesis of NAD from tryptophan via kynurenine; expresssion is upregulated upon telomere uncapping; regulated by Hst1p and Aft2p
Localization:
Intensity:
Fold change:
Significance:
-
C’ GFP library in SD

cytosol22.89 -
N' NOP1pr-GFP in SD
cytosol120.289 -
N' TEF2pr-mCherry in SD
cytosol156.611 -
N' NATIVEpr-GFP in SD
below threshold18.8344 -
N' TEF2pr-VC and Cyto-VN in SD

#N/A0 -
C’ GFP library in SD+DTT
cytosol37.551.64Yes -
C’ GFP library in SD+H2O2

cytosol21.660.94No -
C’ GFP library in Starvation Media
cytosol16.520.72No -
C’ GFP library on the background of Pup2-DaMP

cytosol -
C’ GFP library on the background of CCT mutant

cytosol22.60190.987109No
